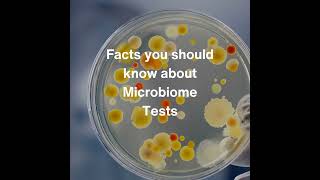

Current healthcare system lacks effective diagnostic tools to discover molecular signatures underlying chronic diseases & cancer at an early stage & delivers ineffective treatments, resulting in late diagnosis, adverse health outcomes & low survival rates.
What if we could identify these hard to detect signatures & eliminate them by precision medicine so that disease does not even exist?
Our biochemistry + mathematics platform collects, analyzes & interprets molecular data to discover pre-disease molecular signatures for metabolic diseases & cancer & eliminate them using precision therapeutics.
Our machine learnt model can predict the insulin response to 300 foods plus foods.
Our oral cancer early detect test measures molecular mechanisms preceding tumour development & construct nutritional therapeutics to eliminate carcinogenic & mutagenic molecules before cancer manifests. The test also caters to preventive recurrence for patients already in an advanced stage of disease.
Shared 3 weeks ago
13 views
The Energetic Physics of Mitochondria- Why Breakdown Here Causes Cancer & Degeneration #mitochondria
Shared 2 months ago
19 views
Shared 4 months ago
19 views
Shared 4 months ago
32 views
Shared 5 months ago
40 views
Shared 5 months ago
28 views
Shared 7 months ago
22 views
Shared 7 months ago
19 views
Shared 8 months ago
53 views
Shared 10 months ago
29 views
Shared 10 months ago
35 views
Shared 1 year ago
20 views
Shared 1 year ago
14 views
Shared 1 year ago
12 views
Shared 1 year ago
13 views
Shared 1 year ago
45 views
Shared 1 year ago
7 views
Shared 1 year ago
14 views
Shared 1 year ago
25 views
Shared 1 year ago
16 views
Shared 1 year ago
23 views
Shared 1 year ago
13 views
Shared 1 year ago
51 views
Shared 1 year ago
454 views
Shared 1 year ago
209 views
Shared 1 year ago
27 views
Shared 1 year ago
6 views
Shared 1 year ago
16 views
Shared 1 year ago
20 views
Shared 1 year ago
10 views
Shared 1 year ago
14 views
Shared 1 year ago
64 views
Shared 1 year ago
14 views
Shared 1 year ago
19 views
Shared 1 year ago
8 views
Shared 1 year ago
19 views
Shared 1 year ago
30 views
Shared 1 year ago
3 views
Shared 1 year ago
17 views
Shared 1 year ago
23 views
Shared 1 year ago
26 views
Shared 1 year ago
24 views
Shared 1 year ago
400 views
Shared 1 year ago
7 views
Shared 1 year ago
20 views
Shared 1 year ago
3 views
Shared 1 year ago
28 views
Shared 1 year ago
15 views
Shared 1 year ago
42 views